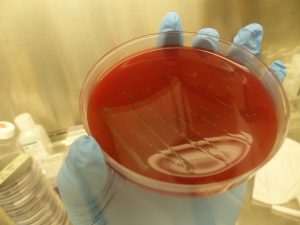

Eilís Quinn, Eye on the Arctic
Eilís Quinn is an award-winning journalist and manages Radio Canada International’s Eye on the Arctic news cooperation project. Eilís has reported from the Arctic regions of all eight circumpolar countries and has produced numerous documentary and multimedia series about climate change and the issues facing Indigenous peoples in the North.
Her investigative report "Death in the Arctic: A community grieves, a father fights for change," about the murder of Robert Adams, a 19-year-old Inuk man from Arctic Quebec, received the silver medal for “Best Investigative Article or Series” at the 2019 Canadian Online Publishing Awards. The project also received an honourable mention for excellence in reporting on trauma at the 2019 Dart Awards in New York City.
Her report “The Arctic Railway: Building a future or destroying a culture?” on the impact a multi-billion euro infrastructure project would have on Indigenous communities in Arctic Europe was a finalist at the 2019 Canadian Association of Journalists award in the online investigative category.
Her multimedia project on the health challenges in the Canadian Arctic, "Bridging the Divide," was a finalist at the 2012 Webby Awards.
Her work on climate change in the Arctic has also been featured on the TV science program Découverte, as well as Le Téléjournal, the French-Language CBC’s flagship news cast.
Eilís has worked for media organizations in Canada and the United States and as a TV host for the Discovery/BBC Worldwide series "Best in China."